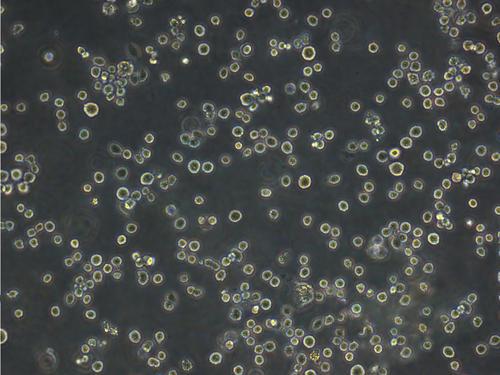
人T淋巴细胞系

人T淋巴细胞系 用途与合成方法
人T淋巴细胞系是HUT78(ATCCTIB161)的克隆系(Callo,RC,etal)。细胞表面带有CD3、CD4标记。研究表明,该细胞系对人体免疫缺陷病毒(HIV-1)敏感,可用于检测、分离和增殖HIV-1,也可用于其它人类Tcell病毒的研究。T淋巴细胞(T lymphocyte)简称T细胞,是由来源于骨髓的淋巴干细胞,在胸腺中分化、发育成熟后,通过淋巴和血液循环而分布到全身的免疫器官和组织中发挥免疫功能。
人T淋巴细胞系
人T淋巴细胞系供应商 更多
人T淋巴细胞系新闻专题 更多
2021-04-20
人T淋巴细胞系的应用


